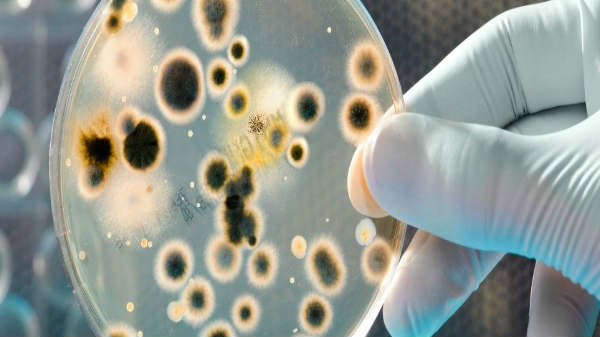
340  கோடி ஆண்டுகள் படிக்கற்கள்:

5ஆயிரம் ஆண்டில் மனித இனம் ஏலியனாக மாறும்- பதற வைக்கும் ஆய்வு.!
ஆனால் இந்த மனித இனத்தின் உடல் உறுப்புகள் எப்படி இருக்கும். மனித இனம் இருக்குமா என்றால் பெரும் கேள்வி குறியாக விளங்குகின்றது. இந்நிலையில் மனித இனம் ஏலியனை போல் மாறிவிடும்.
இந்த பூமி தோன்றிய போது, மனித இனம் எப்படி இருக்கும் என்றாலும் நமக்கு தலையே சுற்றுகின்றது. அதேபோல, 5 ஆயிரம் ஆண்டுகள் கழித்து பார்த்தால் மனித இனம் எப்படி இருக்கும் என்று நினைத்தாலும், தலை சுழற்றி மயக்கம் வரும்.

ஆனால் இந்த மனித இனத்தின் உடல் உறுப்புகள் எப்படி இருக்கும். மனித இனம் இருக்குமா என்றால் பெரும் கேள்வி குறியாக விளங்குகின்றது. இந்நிலையில் மனித இனம் ஏலியனை போல் மாறிவிடும்.
வேற்றுகிரமும் பூமியோடு சேர்வதால் மனித இனம் மாறுப்பட்ட காலநிலைக்கு ஏற்றவாறு தனது பரிமாணத்தை மாற்றிக்கொள்ளும்.

பூமி-நிலவு வயது:
பூமி மற்றும் நிலவு ஆகியவற்றின் வயது இதுவரை கணிக்கப்பட்டதை விட கூடுதலாக 6 கோடி ஆண்டுகள் இருக்கலாம் என ஆய்வில் தெரியவந்துள்ளது. பிரான்ஸ், லோரைன் பல்கலைக்கழகத்தைச் சேர்ந்த புவி அறிவியலாளர்கள், ஐசோடோபிக் சமிக்ஞைகள் மூலம் ஆய்வு செய்ததில் பூமி மற்றும் நிலவின் வயதை குறைவாகக் கணித்தது தெரியவந்தது.

10 ஆயிரம் ஆண்டுக்கு பிறகு பூமி:
சூரியக் குடும்பம் உருவான 10 கோடி ஆண்டுகளுக்குப் பிறகு பூமி உருவாகியிருக்க வேண்டும் என அறிவியலாளர்கள் கருதி வந்தனர். ஆனால், புதிய ஆய்வின் படி சூரியக் குடும்பம் தோன்றிய 4 கோடி ஆண்டுகளுக்குப் பின் பூமி உருப்பெற்றிருக்க வேண்டும் என தற்போது தெரியவந்துள்ளது.
340 கோடி ஆண்டுகள் படிக்கற்கள்:
ஆய்வாளர்கள் கிலாமே அவிஸ் மற்றும் பெர்னாட் மார்டி ஆகியோர் தென்னாப்பிரிக்கா மற்றும் ஆஸ்திரேலியாவில் கிடைத்த படிகக்கல்லில் (குவார்ட்ஸ்) இருந்த ஜெனான் வாயுவை ஆய்வு செய்தனர். அவற்றின் வயது முறையே 340 மற்றும் 270 கோடி ஆண்டுகள் எனத் தெரிய வந்தது.
அந்தப் படிகக்கல்லில் இருந்த ஜெனான் வாயுவின் ஐஸோடோப்பிக் விகிதாச் சாரத்தை தற்போதைய நிலையு டன் ஒப்பிட்டு வயதைக் கண்டறிந்தனர். இதன் மூலம் புவியின் வயது, தற்போது கருதப்படுவதை விட அதிகம் என்பது நிரூபணம் ஆகியுள்ளது.

6 கோடி ஆண்டுகள் வயது அதிகம்:
இது தொடர்பாக அவிஸ் கூறுகையில், "பூமி எப்போது உருவானது என்பதைத் துல்லியமாகக் கூற முடியாது. தற்போதைய ஆய்வின்படி, இதுவரை கருதப்பட்டுவந்த பூமியின் வயதை விட, 6 கோடி ஆண்டுகள் அதிகம் எனத் தெரிய வந்துள்ளது" என்றார்.

பூமியில் ஏற்படும் சூழல்:
இந்த உலகம் தற்போது 2 ஆயிரம் ஆண்டில் நம்முடன் சேர்ந்து இயங்கி கொண்டிருகின்றது. இன்னும் 5 ஆயிரம் ஆண்டில் பூமி மற்றும் மனித இனத்தின் நிலை என்னவென்று உலகப் புகழ்பெற்ற பாலியே ஆர்ந்த்ரோ பாலிஜிஸ்ட் ஆய்வுப்படி பூமியில் ஏற்படும் சூழல்கள் குறித்து கூறப்பட்டுள்ளது.
5 ஆயிரம் ஆண்டில் மூன்று சூழல்கள் ஏற்படும்

தண்ணீர் உலகம்:
வாட்டர் வேல்டு என்று கூறப்படுகின்றது. பூமி வெப்ப மயமாவதால், உலகத்தில் உள்ள பனிமலைகள் அனைத்தும் உருகி உலகம் தண்ணீரால் சூழப்படும்.
அப்போது பூமி பரப்பு முழுக்க தண்ணீரில் மூழ்கினால், மனிதன இனம் பரிமாணப்வளர்ச்சி ஏற்பட்டு, தண்ணீரில் வசிக்க ஏதுவாக வெப் பிங்கர்ஸ் என்படும் விரல்களுக்குகிடையே சவ்வு போல், கால் மற்றும் கைகளில் வரும். நீரில் நீந்த ஏதுவாகம் இது அமையும்.

ஆழ்கடலில் கண்ணுக்கு வெளிச்சம்:
ஆழ்கடலில் சூரிய வெளிச்சம் படத இடத்தில் மனித இனம் இருந்தாலும், கண் பார்வைக்கு ஏதுவாக நிக்டிடேட்டிங் மெம்ரேன் உருவாகும். இது எக்ஸ்ட்ரா புரொடக்டிங் ஐ லீனர் எனப்படும்.

வேற்றுகிரகம் பூமியோடு இணையும்:
பிளானெட் கோனலாய் சேஷன் எனப்படும் பூமி மற்றொரு கிரகத்தோடு இணையும். நாம் ஆங்கில படங்களில் பார்த்து இருப்போம். வேற்றுகிரக வாசிகளும், மனித இனமும் கலக்க நேரிடும்.

கடல் உணவு ஏற்றார் போல் மாறும்:
நாம் நீர் வாழ் உயிரினங்கள் போல் ஆகிவிடுவதால், நாம் திரவ நிலையில் இருக்கும் உணவுகளைத்தான் எடுத்துக் கொள்ள முடியும். இதனால் மனிதனின் தாடைகள் பலம் குறைந்து முக அமைப்பும் மாறும்.

இரண்டாம் பனி உலகம்:
இரண்டாம் பனி உலகம் எனப்படுவது உலகம் முழுக்கவும் பனி சூழ்ந்த நிலை ஏற்படும். சூரியனின் கதிர்கள் குறைந்தும், அதிக குளிர்ச்சியை ஏற்படும். இதானல் இரண்டாம் பனி உலகம் ஏற்படும்.

எரிமலைகள் வெடிக்கும்:
உலகத்தில் உள்ள அனைத்து எரிமலைகளும் வெடித்து சாம்பல்களை கக்கும். இதனால், பூமியின் அசாதாரண நிலை ஏற்பட்டு இதற்கு ஏற்றார் போல், மனித இனத்திற்கு தோல் முகம், உடல் உறுப்புகளிலும் மாற்றம் ஏற்படும் என்று கூறப்படுகின்றது.


Click it and Unblock the Notifications